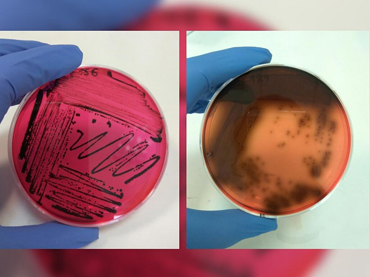
FOOD QUALITY & SAFETY

ITAP is the unique research institute in the wider public sector that deals with the quality, safety, processing and preservation of food products of plant and animal origin.
INSTITUTE OF TECHNOLOGY OF AGRICULTURAL PRODUCTS

RESEARCH
It covers core research areas in Food, Wine & beverage Science –Technology with an experienced research scientific staff

LABORATORIES ACCREDITED to ELOT EN ISO/IEC 17025
Physico-chemical and Microbiological Analysis Laboratory- Genetic Identification Laboratory are accredited to ELOT EN ISO/IEC 17025

TECHNICAL ADVICE TO FOOD INDUSTRY
Process optimization of commercial products- Food Quality assurance and safety – Development of new products with novel technologies.

DISSEMINATION OF KNOWLEDGE
Publications in international and national scientific journals, announcements in scientific conferences and workshops, in press, media and social media.

KNOWLEDGE TRANSFER
The transfer of know-how/knowledge the food industry is carried out in cooperation with the industry of the sector.

TRAINING/SUPERVISING
Training of students of AEI, TEI, IEK, staff of the Ministry of Rural Development & Food and Agricultural Industries
RESEARCH AREAS OF ITAP
RESEARCH AREAS OF INTEREST – Institute of Technology of Agricultural Products-ITAP:
SERVICES OF INSTITUTE OF TECHNOLOGY OF AGRICULTURAL PRODUCTS-ITAP
ITAP provides services with specialized analysis of food and agricultural products, studies & technical support in order to solve problems during food processing, to assure the quality and hygiene of foodstuffs and to develop new products using modern methods and technologies .

PHYSICO-CHEMICAL ANALYSIS OF FOOD PRODUCTS
- Nutrition labeling of foodstuff
- Determination of additives and preservatives
- Determination of mycotoxins
- Various food analysis

MICROBIOLOGICAL ANALYSIS OF FOOD PRODUCTS
- Enumeration methods
- Detection and enumeration methods
- Microbiological analysis of water

GENETIC ANALYSIS OF AGRICULTURAL PRODUCTS
- Qualitative detection of genetic modificationsv in seed and flour using PCR and the specific primers 35S, NOS.

SENSORY ANALYSIS OF FOOD PRODUCTS
- Sensory Analysis of foodstuffs
- Comparative organoleptic evaluation of similar foods
- Correlation of quality indices with organoleptic criteria
- Sensory Analysis of Table Olives

MOLECULAR ANALYSIS OF FOOD PRODUCTS
- Detection and characterization of foodborne pathogens, spoilage and technological microorganisms related to foods
- Monitoring of food microbiota during storage
- Direct monitoring of food microbiota from food

CHEMICAL & MICROBIOLOGICAL ANALYSIS OF MUSTS, WINES & SPIRITS
- Chemical analysis
- Microbiological analysis
- Pack of analyses for grape must
- Pack of analyses for wine
UPCOMING CONFERENCES – SEMINARS – WORKSHOPS – EVENTS
ASSOCIATES/CUSTOMERS OF ITAP
INSTITUTE OF TECHNOLOGY OF AGRICULTURAL PRODUCTS – ITAP
NEWS ITAP
All latest news and events of INSTITUTE OF TECHNOLOGY OF AGRICULTURAL PRODUCTS-ITAP

ΑΝΑΡΤΗΣΗ ΓΙΑ ΤΗ ΔΙΑΔΙΚΑΣΙΑ ΕΝΣΤΑΣΕΩΝ – Αποδοχή του πρακτικού της Επιτροπής Αξιολόγησης της αριθμ. 1061/21313/23.04.2024 Πρόσκληση Εκδήλωσης Ενδιαφέροντος για τις ανάγκες υλοποίησης του Έργου «Εφαρμογή καινοτόμων μεθόδων και τεχνολογιών επεξεργασίας του ελαιοκάρπου για την υψηλής απόδοσης παραγωγή ελαιολάδου και πάστας ελιάς με βελτιωμένα ποιοτικά και διατροφικά χαρακτηριστικά»
27/05/2024
Αποδοχή του πρακτικού της Επιτροπής Αξιολόγησης της αριθμ. 1061/21313/23.04.2024 Πρόσκληση Εκδήλωσης Ενδιαφέροντος. Σύναψη μίας (1) σύμβασης μίσθωσης έργου για τις ανάγκες υλοποίησης του Έργου «Εφαρμο...Read More

ΑΝΑΡΤΗΣΗ ΓΙΑ ΤΗ ΔΙΑΔΙΚΑΣΙΑ ΕΝΣΤΑΣΕΩΝ – Αποδοχή του πρακτικού της Επιτροπής Αξιολόγησης της αριθμ.48/1115/09.01.2024 Πρόσκλησης Εκδήλωσης Ενδιαφέροντος για τις ανάγκες υλοποίησης του Έργου με τίτλο «Excellence hub in green technologies: Introducing innovation ecosystems in the Mediterranean food value chain»
05/04/2024
Αποδοχή του πρακτικού της Επιτροπής Αξιολόγησης της αριθμ.48/1115/09.01.2024 Πρόσκλησης Εκδήλωσης Ενδιαφέροντος. Σύναψη μίας (1) σύμβαση μίσθωσης έργου για τις ανάγκες υλοποίησης του Έργου με τίτλο «E...Read More

Πρόσκληση εκδήλωσης ενδιαφέροντος για την υποβολή πρότασης προς σύναψη μίας (1) σύμβασης μίσθωσης εργασίας Ιδιωτικού Δικαίου ορισμένου Χρόνου, για τις ανάγκες υλοποίησης του Έργου “Μελέτη και αξιολόγηση των ποιοτικών χαρακτηριστικών Ελληνικού γάλακτος”.
20/03/2024
Έχοντας υπόψη την αριθμ. 19 απόφαση της 04ης/13.03.2024 Συνεδρίασης της Επιτροπής Αγροτικής Έρευνας, ο ΕΛΛΗΝΙΚΟΣ ΓΕΩΡΓΙΚΟΣ ΟΡΓΑΝΙΣΜΟΣ – ΔΗΜΗΤΡΑ / Ινστιτούτο Τεχνολογίας Αγροτικών Προϊόντων εκδηλώνει ε...Read More